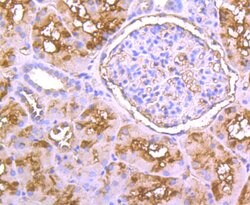
Invitrogen PPM1A Polyclonal Antibody 100 &mu;L; Unconjugated:Antibodies,

missing translation for 'onlineSavingsMsg'
Learn More
Learn More
Invitrogen™ PPM1A Polyclonal Antibody


Rabbit Polyclonal Antibody
Brand: Invitrogen™ PA585938
This item is not returnable.
View return policy
Description
PPM1A Polyclonal Antibody for Western Blot, ICC/IF, IHC (P), Flow
PPM1A (Protein phosphatase 1A) is also named as PPPM1A and belongs to the PP2C family. It is a serine/threonine protein phosphatase that is essential for regulating cellular stress responses in eukaryotes. PPM1A plays an important role in tumor suppression and that it negatively controls many signaling pathways which are critical for trophoblast invasion. This protein distributes in both the cytoplasm and nucleus of mammalian cells. It has 2 isoforms produced by alternative splicing.
Specifications
| PPM1A | |
| Polyclonal | |
| Unconjugated | |
| PPM1A | |
| 2310003C21Rik; 2900017D14Rik; AI427932; AU017636; IA; MMPa-2; Mpp alpha; MPPa-1; Pp2c1; PP2CA; PP2Calpha; PP2C-alpha; PPM1A; PPPM1A; Protein phosphatase 1A; protein phosphatase 1A (formerly 2C), magnesium-dependent, alpha isoform; protein phosphatase 1A, magnesium dependent, alpha isoform; protein phosphatase 2C isoform alpha; Protein phosphatase IA; Protein phosphatase type 1A (formely 2C) Mg-dependent alpha isoform; Protein phosphatase type 1A (formely 2C), Mg-dependent, alpha isoform; protein phosphatase, Mg2+/Mn2+ dependent 1A; protein phosphatase, Mg2+/Mn2+ dependent, 1A | |
| Rabbit | |
| Protein A | |
| RUO | |
| 19042, 24666, 5494 | |
| Store at 4°C short term. For long term storage, store at -20°C, avoiding freeze/thaw cycles. | |
| Liquid |
| Flow Cytometry, Immunohistochemistry (Paraffin), Western Blot, Immunocytochemistry | |
| 1 mg/mL | |
| PBS with 0.2% BSA, 50% Glycerol and 0.05% sodium azide; pH 7.4 | |
| P20650, P35813, P49443 | |
| PPM1A | |
| Recombinant protein within human PP2C alpha aa 42-330. | |
| 100 μL | |
| Primary | |
| Human, Mouse, Rat | |
| Antibody | |
| IgG |
Product Content Correction
Your input is important to us. Please complete this form to provide feedback related to the content on this product.
Product Title
Spot an opportunity for improvement?Share a Content Correction